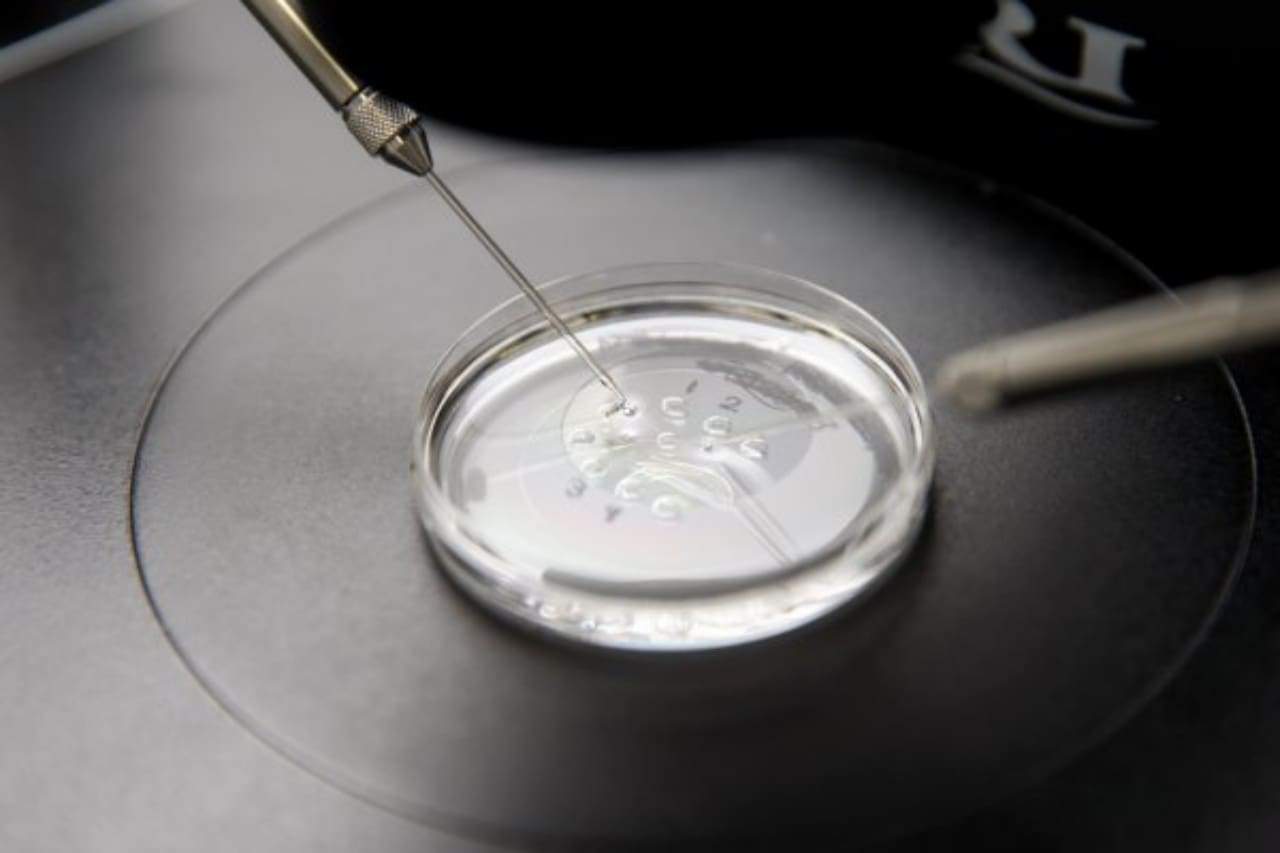

The Rise of Intentional Single Mothers
A recent, gut-wrenching story from the New York Times should be required reading for anyone thinking about employing In vitro fertilization. After a mix-up, two California couples ended up carrying, birthing and raising each other’s baby girls for several months. Ultimately, the two sets of parents made the “unbearable decision” to switch children, choosing custody of their genetic daughter over the one they had welcomed and nursed and loved.
Though describing a rare occurrence, the story illustrates why this under-regulated industry needs more oversight, as the author notes. What is missed in the piece, however, is that the main problems with this kind of assisted reproduction aren’t the freak accidents with things that might but probably won’t go wrong. The main issue is the any number of things that go wrong anytime babies are created in ways that ignore God’s design for the family.
For example, just as tragic as parents learning they must give up a baby they thought was theirs is when one genetic parent conceives a child without wanting the other parent to be involved in that child’s life. Unlike a rare embryo mix-up, this kind of parental alienation is common in the fertility industry. The Guardian recently reported that the number of single women seeking fertility treatments in the U.K. has more than tripled in the last decade, outpacing the growth of IVF in general and even the growth of same-sex couples seeking to make a baby.
In her Guardian article, Amelia Hill quoted several women who chose to become solo mothers. They feel “empowered” because they “did it on their own.” Typically, the father relegates himself to the status of “sperm donor.” One single 45-year-old, conscious of her ticking biological clock, put it this way:
I’m never gonna meet anybody. … I think doing it without a partner is probably a bit easier. … I worried whether [my daughter would] mind not having a dad. … But now I think it’s good not to have rushed into a relationship that might not have worked simply for that reason.
According to the mother, the experience has been liberating. “People would ask: ‘Did he leave you—did you leave him?’ and it felt good to be able to say: ‘Nope, I did it on my own!’”
But she didn’t do it on her own. No woman or man has a child on his or her own. In her case and in the case of each of the thousands of single women in the West turning to science to give them children, there is always a father involved.
In any other situation that a father is alive but absent, he would be considered a “deadbeat.” The child and the mother are rightly considered abandoned and wronged. Somehow, in this case, choosing the abandonment is empowerment and progress for women.
All the euphemisms in the world will not change what has happened to the child. Intentionally conceiving with the intent to raise a child without the father creates the same painful situation as if the father left. The consequences are not altered because technology was utilized.
The rise of intentionally single mothers and same-sex couples hiring surrogates and “donors” has exposed how selective our society is with compassion. Major magazines run long-form articles about rare and terrible cases in which children are born to the wrong parents, but if a baby is taken from either their mother or father as the plan we are supposed to celebrate “freedom” and autonomy. And the children are not allowed to complain.
Each assumption behind these far-more common tragedies is adult-centric. Babies are a right that adults can demand. Adult happiness is the priority of the child’s wellbeing. Marriage and moms and dads are optional aspects of childrearing. The family can be remolded and deconstructed at will.
Tragically, many Christians approach surrogacy and embryo-destructive IVF with the same “the kids will be alright” assumption, as long as adults get what they want. This is completely backwards. The first consideration when it comes to marriage and procreation is what God intended. This allows us to know what is best for children, what and whom they have a right to, and how children were meant to come into the world.
Failing to answer these questions has subjected children to serious harm, even when all the technology goes “right.”
ABOUT THE AUTHOR

John Stonestreet is President of The Chuck Colson Center for Christian Worldview which seeks to build and resource a movement of Christians committed to living and defending the Christian worldview. The Center was begun by Chuck Colson in 1991 as a radio broadcast called BreakPoint, of which John now serves as co-host. John is a popular public speaker and the co-author of four books including A Practical Guide to Culture and Restoring All Things. He and his wife, Sarah, have three daughters and recently welcomed a baby boy into their family.




